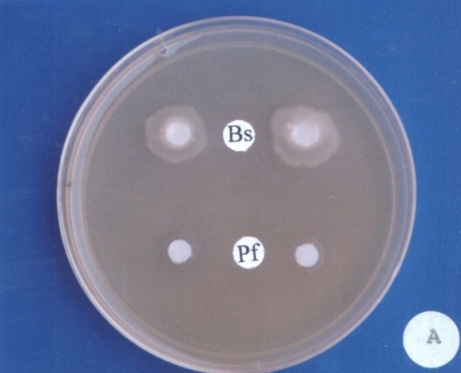

Dilip Kumar Sharma
Vardhaman Mahaveer Open Universiy, Kota, Rajasthan, India
Address for corresponding Author
Dr. Dilip Kumar Sharma
Vardhaman Mahaveer Open Universiy, Kota, Rajasthan, India
Abstract
Background: The fungal and bacterial antagonist were used to study their antimicrobial efficacy against Xanthomonas axonopodis pv. vesicatoria (Doidge) Dye in chilli causing bacterial leaf spot. Objective: The present study indicates the effective control of the pathogen and reduced the disease incidence significantly in non-hazardous manner by using fungal and bacterial antagonists. Materials and methods: For the control of pathogen 5 fungal and 2 bacterial antagonists namely Gliocladium virens, Trichoderma viride, T. harzinum, Stachybhotrys atra, Penicillium chrysogenum and Bacillus subtilis, Pseudomonas fluorescence respectively used by filter paper disc assay, seeded agar method and standard blotter methods. Results: Out of used fungal antagonists Trichoderma viride found most effective which improve seed germination and control of pathogen followed by Penicillium chrysogenum as compared to check in all the method. In filter paper method, bacterial antagonist Bacillus subtilis found effective against the pathogen followed by Pseudomonas fluorescence in control of various isolates of XAV.
Keywords: Antibacterial, chilli, fungal antagonists, bacterial antagonists, Xanthomonas axonopodis pv. vesicatoria
Introduction
Use of bio-agent for control of several plant diseases is an alternative approach in comparison of chemical fungicides because these are safe, effective and eco-friendly in comparison of chemical (Ramamoorthy et al., 2002). The most commonly used bioagents are Gliocladium virens, Trichoderma harzianum, T. veridae, Agrobacterium radiobacter, Pseudomonas fluorescens, Baccillus subtilis, soil-borne fungi, bacteria and Actinomycetes as antagonist against several pathogenic microbes (Ramamoorthy et al., 2002; Agrios, 2005; Gravel et al., 2005; Intana et al., 2008; Montealegre et al., 2010; Khare et al., 2010; Christy Jeyaseelan et al., 2012).
The antagonistic reactions include antibiosis, competition and hyper parasitism of (Cook and Baker, 1983; Leelavathi et al., 2014). It is reported that various species of Trichoderma secret approx 40 different types of antibiotics, chemical compounds and many secondary metabolites against microorganisms specially gram positive and negative bacteria. These chemicals or metabolites promote plant growth and yield of crop (Tapwal et al., 2011; Mukherjee et al., 2013; Ruano-Rosa et al., 2014).
Bacterial leaf spot (BLS) disease of sweet pepper (Capsicum annuum) caused by Xanthomonas axonopodis pv. vesicatora is recorded from several countries of eastern and southern Africa, USA, Ethiopia, Kenya, Malawi, Mozambique and South Africa (Black et al., 2001). XAV suspected from symptoms on fruit was confirmed by isolation on semi-selective media including Tween B (McGuire et al., 1986; Jones et al., 2000). In India, bacterial leaf spot disease was first reported from Pune, Maharastra in 1948 by Patel et al. in chilli. In Rajasthan, the disease caused 7.5 to 16.6 per cent loss in the yield of fruits 22-34°C and high humidity for maximum infection (Shekhawat and Chakravarti, 1976; Shekhawat and Chakravarti, 1977). It losses in marketable fruits may be more than 50% (Pohronezny et al., 1992; Anonymous, 2012). The pathogen was found seed-borne (10-15%) and occurs on infected plant debris and weeds (Jones et al., 1986). The incidence was less than 5% persisted from one season to next in crop debris or on weed hosts (Ravinkar et al., 2001).
Xanthomonas axonopodis pv. vesicatora (Doidge) Dye (syn: Xanthomonas campestris pv vesicatoria) (XAV) a gram-negative, rod-shaped bacterium attack on plant (Anonymous, 1996; Thieme et al., 2005; Anonymous, 2016). The bacterial colonies were circular, raised, yellow, mucoid colonies on Tween-80 agar medium. The isolates were gram's negative, KOH solubility test positive, levan negative, lipase activity positive, oxidase negative, starch hydrolyzing, gelatin hydrolyzing, arginine variable, did not reduce nitrate and no rotting of potato tissue occurred. The pathogen induced positive hypersensitivity reaction on tobacco leaves after infiltration and turgidity of leaves was lost within 6-10hrs followed by local necrosis and desiccation of affected leaf tissues after 36 hrs (Bradbury, 1986; Neergaard, 1986; Schaad, 1988; Agarwal, et al., 1989; Saettler et al., 1989; Mortensen, 1994a, b; Anonymous, 1996; Thieme et al. 2005; Anonymous, 2016). The pathogen XAV has been reported to be seed-borne in chilli (Neergaard, 1977; Bradbury, 1986; Richardson, 1990).
Materials and methods
Seed treatment with fungal antagonists in SBM
For the study of effect of antagonists on germination and control of pathogen, the fungal antagonist as Gliocladium virens, Trichoderma viride, T. harzinum, Stachybhotrys atra and Penicillium chrysogenum were used against seed-borne infection of Xanthomonas campestris pv. vesicatoria in chilli. The pure cultures of G. virens, T. viride, T. harzinum, were obtained from Agriculture Research Station (ARS), Navgaon (Alwar) and S. atra and P. chrysogenum were isolated by serial dilution method from the chilli and tomato field soils. All the fungal cultures were raised on PDA (Potato dextrose agar) for the each treatment. In 12 days old culture plates of all the fungal bio-agent, 20 ml of double sterilized distilled water was added to and suspension were obtained in conical flask. The naturally infected seed for each pathogen (100 seeds/treatment in triplicate) were taken soaked in spore suspension of the antagonist for 4 hrs. The seeds were incubated on moistened blotters by standard blotter method (Anonymous, 1985) and per cent seed germination, seedling symptoms incidence of the pathogen and inhibition of the pathogen were recorded on 8th day. The percent control of pathogens was calculated by the following formula:

In vitro evaluation in filter paper disc assay
The pure culture of bacterial antagonists was obtained from Agriculture Research Station (ARS), Durgapura, Jaipur. A lawn on nutrient agar medium with test pathogen was prepared using L-rods and incubates at 30±2°C for 20 min for the better growth of the test pathogen. A disc of (6 mm) Whatman filter paper, sterilized in oven at 140°C for 1 hr was impregnate with culture of antagonist namely Bacillus subtilis and Pseudomonas fluorescence placed on the already prepared lawn of the pathogen. In seeded agar method, wells of 6 mm diameter were yielded on (already seeded) nutrient agar medium using sterilized cork borer and crude suspension of fungal antagonists were place in it. The diameter or zone of inhibition was recorded up to 6 days in intervals of 24 hrs at 25 ± 2°C for each test agent and activity index was calculated. The clearing or zone of inhibition and activity index was calculated by given formula (Bahadauria and Kumar, 2004).

Results and discussion
Seed treatments using fungal antagonists in SBM
The significant improvement in seed germination in infected seeds was observed after treating the seeds with Trichoderma viride (87.5 and 90%) followed by Penicillium chrysogenum (85 and 87.5%) as compared to check (65.5 and 70%) in chilli seed samples ac. nos. Ca-1227 and Ca-1234 respectively infected with XAV. There was reduction in the incidence of the pathogen after treating T. viride (25 and 27.5%) followed by P. chrysogenum (42.5 and 37.5%) in both the samples showed the reduction of pathogen as compared to check (67.5 and 62.5%) respectively. The maximum per cent control of the pathogen shown by T. viride (62.96 and 56%) followed by P. chrysogenum (37.33 and 40%) in both the samples respectively (Table 1). The per cent control of the pathogen was statistically significant (P< 0.05) and relative per cent control of pathogen was as follows:
Trichoderma viride> Penicillium chrysogenum> Gliocladium virens> T. harzinum> Stachybhotrys atra
Table 1. In vitro effect of seed treatment of fungal antagonists on seed germination and control of Xanthomonas campestris pv. axanopodis in chilli
|
S. No. |
Fungal antagonists |
Seed Samples |
|||||
|
Ca-1227 |
Ca-1234 |
||||||
|
Seed germination (%) |
Incidence of pathogen (%) |
Control of pathogen (%) |
Seed germination (%) |
Incidence of pathogen (%) |
Control of pathogen (%) |
||
|
1. |
Check |
65.5 (55.24) |
67.5 (55.24) |
0 (0.00) |
70.0 (56.79) |
62.5 (52.24) |
0 (0.00) |
|
2. |
Trichoderma viride |
87.5** (69.30) |
25.0** (30.0) |
62.96** (51.59) |
90.0 (71.56) |
27.5 (31.63) |
56.00 (48.64) |
|
3. |
Gleocladium virens |
82.5 (65.27) |
37.5** (37.76) |
44.44** (41.55) |
80.0 (63.44) |
40.0 (39.23) |
36.00 (35.15) |
|
4. |
T. harzianum |
77.5 (61.68) |
45.0 (42.13) |
33.3 (35.24) |
77.5 (61.68) |
47.5 (43.57) |
24.00 (28.59) |
|
5. |
Stachybotrys atra |
72.5 (58.37) |
65.0 (53.73) |
03.70 (10.94) |
72.5 (58.37) |
55.0 (47.87) |
12.00 (18.64) |
|
6. |
Penicillium chrysogenum |
85.0** (67.21) |
42.5 (40.69) |
37.33 (36.05) |
87.5 (69.30) |
37.5 (37.76) |
40.00 (38.59) |
|
|
CD at 5% CD at 1% |
5.62 7.70 |
18.39 25.20 |
10.62 14.55 |
9.16 12.55 |
16.55 18.97 |
15.58 21.35 |
Values are the mean of 3 replicates; values in parentheses are angular transformed values.
In vitro evaluation of bacterial antagonists in filter paper disc assay
Against all the 18 morphologically and biochemically different isolates of XAV two bacterial antagonists namely Bacillus subtilis and P. fluorescence were used. The maximum zone of inhibition around the disc, in filter paper disc assay method was shown by the antagonist B. subtilis (15.60 to 16.10 mm) followed by P. fluorescence (11.50 to13.00 mm). The activity index was 2.60 to 2.68 and 1.9 to 2.16 in case of B. subtilis and P. fluorescence respectively (Figure 1A, Table 2). In the present study T. viride gave best control against XAV in chilli followed by P. chrysogenum. In in vitro evaluation of bacterial antagonist against pathogen B. subtilis showed potential control followed by P. fluorescence in filter paper disc method.
Table 2. In vitro evaluation of antimicrobial activity of bacterial antagonists against isolates of Xanthomonas axonopodis pv. vesicatoria in chilli
|
S. No. |
Test Isolates |
Bacterial Antagonists |
|||
|
Pseudomonas fluorescence (Pf) |
Bacillus subtilis (Bs) |
||||
|
Inhibition zone (mm) |
Activity Index |
Inhibition zone (mm) |
Activity Index |
||
|
1 |
Ca-XCV-1 |
12.80 |
2.13 |
15.60 |
2.60 |
|
2 |
Ca-XCV-2 |
12.10 |
2.01 |
15.90 |
2.65 |
|
3 |
Ca-XCV-3 |
13.00 |
2.16 |
15.50 |
2.58 |
|
4 |
Ca-XCV-4 |
11.90 |
1.98 |
15.60 |
2.60 |
|
5 |
Ca-XCV-5 |
11.50 |
1.91 |
16.00 |
2.66 |
|
6 |
Ca-XCV-6 |
12.80 |
2.13 |
16.10 |
2.68 |
|
7 |
Ca-XCV-7 |
11.50 |
1.91 |
15.90 |
2.65 |
|
8 |
Ca-XCV-8 |
11.60 |
1.93 |
15.80 |
2.63 |
|
9 |
Ca-XCV-9 |
12.10 |
2.01 |
15.60 |
2.60 |
|
10 |
Ca-XCV-10 |
12.20 |
2.03 |
16.00 |
2.66 |
|
11 |
Ca-XCV-11 |
12.80 |
2.13 |
15.80 |
2.63 |
|
12 |
Ca-XCV-12 |
12.70 |
2.11 |
15.90 |
2.65 |
|
13 |
Ca-XCV-13 |
12.90 |
2.15 |
15.70 |
2.61 |
|
14 |
Ca-XCV-14 |
11.90 |
1.98 |
16.00 |
2.66 |
|
15 |
Ca-XCV-15 |
12.80 |
2.13 |
15.60 |
2.60 |
|
16 |
Ca-XCV-16 |
12.90 |
2.15 |
16.00 |
2.66 |
|
17 |
Ca-XCV-17 |
13.00 |
2.16 |
16.10 |
2.68 |
|
18 |
Ca-XCV-18 |
12.80 |
2.13 |
15.90 |
2.65 |
*Diameter of filter paper disc (6 mm) included inhibition zone in check (IZ = Inhibition Zone; AI = Activity Index).
Figure 1. Control of Xanthomonas campestris pv. vesicatoria isolated from seeds of chilli by Bacillus subtilis (Bs) and Pseudomonas fluorescence (Pf) on seeded nutrient agar medium. Note the zone of inhibition around the paper discs
In earlier studies, P. fluorescence found effective against several bacterial pathogens such as X. c. pv. citri, the inducer of citrus canker (Unnamalai and Gnanamanickam, 1984), X. oryzae pv. oryzae, causing bacterial blight of rice (Sivamani et al., 1987), Erwinia carotovora sub sp. carotovora (Kloepper et al., 1980), X. c. pv. malvacearum causing bacterial leaf sheath blight of cotton (Mondal et al., 1999) and X. axonopodis pv. vignaerditae causing bacterial leaf spot in mungbean (Dutta et al., 2005). It was observed that seed treatment with phylloplane bacteria Bacillus spp. reduced the X. axonopodis pv. vignaeraditae (Borah et al., 2000). A biformulation prepared (Plb. 3 isolate of Bacilluis spp. + inert carrier (talc) at different ratio + carboxy methyl cellulose) and 10% of total weight (spore power and talc as sticker) was found to be effective in producing inhibition zone of varying sized in spot test against different pathovars of X. a. pv. campestris (13 mm), X. a. pv. citri (20 mm), X. a. pv. malvacearum (10 mm), X. a. pv. mangiferaeindicae (16 mm) and X. oryzae pv. oryzae (18 mm) (Patro et al., 2004).
In talc based formulation of P. fluorescens in glass house, revealed that bacterization of rice seed with the formulation followed by its two foliar sprays gave 61% disease control (Thind and Singh, 2004). Local isolation of P. fluorescens showed potential bio-control agent against R. solanacearum (Nath et al., 2004). A strain of P. putida isolation from pepper fruits was able to inhibit a wide spectrum of pathogens including 5 pathovars of P. syringae in in vitro study. P. fluorescence and Bacillus polymyxa have been found to delay the development and reduce the incidence of bacterial wilt (Shekhawat et al., 1983; Shekhawat et al., 1992; Mishghi et al., 1992). Several fluorescent pseudomonads were isolated from cotton rhizosphere (Laha, 1994). Out of 48 isolates only 9 were found antagonistic to Xanthomonas campestris pv. malvacearum (Xcm). In cotton B. subtilis has been reported as an excellent antagonistic against Xcm (Safiazov et al., 1995).
P. fluorescence produces various compounds that suppress the growth of R. solanacearum and induces systemic resistance in the plant (Li et al., 2011; Park et al., 2009; Alsohim et al., 2014). B. subtilis induce systemic resistance; improve plant growth in plants by secreting by several types of lipopeptides or secondary metabolites (Ongena et al., 2007; Kloepper et al., 2004; Bernal et al., 2002). Pre-application of biocontrol agents prevent the disease attack successfully (Ippolito and Nigro, 2000; Yendyo et al., 2017).
In in vitro study T. harzianum showed antimicrobial properties against both bacteria and fungi. It showed maximum antagonistic activity on A. terreus, A. fumigatus, A. clavatus and on clinical isolates namely Staphylococcus aureus, E. coli and Klebsiella. The minimum inhibitory concentration of T. harzianum on fungal isolates ranges from 100 150 μl/ml and for bacterial isolates ranges from 50 100 μl/ml of media. At 100μl/ml concentrations A. fumigatus, A. flavus, A. candidus, Cladosporium, Rhizopus were found to be inhibited whereas A. niger, Fusarium graminarium, F. semitectum, A. terreus were found to inhibit by the T. harzianum extract at 150 μl/ml (Leelavathi et al., 2014). Strain of Trichoderma showed a various degree of inhibition to various plant pathogens. T. harzianum tested against S. aureus, Proteus, E. coli, Klebsiella and found to be affective at 100 μl/ml concentrations (Parshikov et al. 2002; Fethi Bel Haj 2008; Nashwa et al., 2008; Jegathambigai et al., 2009). The MIC ranges from 100 150 μl/ml for fungal isolates and 50-100μl/ml for bacterial isolates (Leelavathi et al., 2014).
In another studies R. solanacearum controlled by B. subtilis and T. harzianum in potato or tobacco or tomato diseases (Lemessa and zeller, 2007; Sharma 2007; Aliye et al., 2008; Maketon et al., 2008; Ji et al., 2008; Chen et al., 2012). B. subtilis was used against infection of Arabidopsis roots by Pseudomonas syringae (Bais et al., 2004). Black rot caused X. c. pv. campestris in brassica controlled by strain of Bacillus subtilis in Zimbabwe (Monteiro et al., 2005; Wulff et al., 2002). In evaluation of spray programs containing famoxadone plus cymoxanil, acibenzolar-Smethyl and B. subtilis compared to copper sprays for management of bacterial spot on tomato was found effective against Xcv (Robert, 2008). Endophytic Streptomyces spp. and T. harzianum used as biocontrol agents of rice against bacterial leaf blight (Harman et al., 2004; Hastuti et al., 2012).
Conclusion
The fungal and bacterial antagonist were used to study their antimicrobial efficacy against Xanthomonas axonopodis pv. vesicatoria (Doidge) Dye and indicates the effective control of the pathogen and reduced the disease incidence significantly in non-hazardous manner by using fungal and bacterial antagonists. Out of used fungal antagonists Trichoderma viride found most effective which improve seed germination and control of pathogen followed by Penicillium chrysogenum as compared to check in all the method. In filter paper method, bacterial antagonist Bacillus subtilis found effective against the pathogen followed by Pseudomonas fluorescence in control of various isolates of XAV. The treatment also improved seed germination and control of pathogen as compared to check.
Acknowledgement
Author is also grateful to Prof. Ashok Sharma, vice-chancellor, VMOU, Kota; Prof. kailash Agrawal, University of Rajasthan, Jaipur, Principal, Agrawal P.G. College, Jaipur, for their valuable guidance and faculty members of P.G. Department of Botany, Agrawal PG College, Jaipur for valuable support. The author is also thankful to all the scientists whom work is cited and could not acknowledge unknowingly and persons that directly or indirectly engaged in writing in this paper and during practical work.
References
Agarwal PC, Mortensen CN, Mathur SB. 1989. Seed-borne diseases and seed health testing of rice. Technical Bull. No. 3, Phytopathology Papers No. 30. Danish government institute of seed pathology for developing countries (DGISP), Copenhagen & CAB International Mycological Institute, (CMI) UK, pp. 106.
Agrios GN. 2005. Plant pathology, 5th ed., Elsevier Academic Press, Oxford, UK.
Aliye N, Fininsa C, Hiskias Y. 2008. Evaluation of rhizosphere bacterial antagonists for their potential to bio-protect potato (Solanum tuberosum) against bacterial wilt (Raistonia solanacearum). Biological Control 47:282-288.
Anonymous. 1985. International seed rules for seed testing International Seed Testing Association (ISTA). Seed Science & Technology 4(3-49):50-177.
Anonymous. 1996. EPPO quarantine pest. 1996. Data Sheets on Quarantine Pests-Xanthomonas vesicatoria. Prepared by CABI and EPPO for the EU under contract 90/399003.
Anonymous. 2012. University of Connecticut-integrated pest management. Managing bacterial leaf spot in pepper. Archived from the original on January 1, 1970. Retrieved October 24, 2012.
Anonymous. 2016. Bacterial leaf spot (Xanthomonas campestris). UMass Extension Center for Agriculture. Retrieved 19 July 2016.
Bahadauria S, Kumar P. 2004. Anti-bacterial activity of some extracts of Lowsonia alba, Solanum dulcamara and Allium sativum against four pathogenic bacteria. Journal of Phytological Research 17(2):191-193.
Bais HP, Fall R, Vivanco JM. 2004. Biocontrol of Bacillus subtilis against infection of Arabidopsis roots by Pseudomonas syringae is facilitiated by biofilm formation and surfactin production. Plant Physiology 134:307-319
Black R, Seal S, Zakia A, Nono-Womdium R, Swai I. 2001. Bacterial spot (Xanthomonas campestris pv. vesicatoria) of tomato and sweet pepper in Tanzania. Plant Pathology 50(6):810.
Borah PK, Jindal JK, Verma JP. 2000. Biological management of bacterial leaf spot of mungbean caused by Xanthomonas axonopodis pv. vignaeradiatae. Indian Phytopathology 53:384-394.
Bradbury JF. 1986. Guide to Plant Pathogenic Bacteria. CAB International Mycological Institute (CMI), UK pp. 332.
Chen Y, Yan F, Chai Y, Liu H, Kolter R, Losick R, Jian-hua Guo. 2012. Biocontrol of tomato wilt disease by Bacillus subtilis isolates from natural environments depends on conserved genes mediating biofilm formation. Environmental Microbiology 1-17.
Christy Jeyaseelan E, Tharmila S, Niranjan K. 2012. Antagonistic activity of Trichoderma spp. and Bacillus spp. against Pythium aphanidermatum isolated from tomato damping off. Archives of Applied Science Research 4 (4):1623-1627.
Cook RJ, Baker KF. 1983. The nature and practice of biological control of plant pathogens. The American Phytopathological Society, St. Paul, MN, p. 539.
Dutta S, Singh RP, Jindal JK. 2005. Effect of antagonistic bacterial and plant defence activators on management of bacterial leaf spot of mungbean. Indian Phytopathology 58(3):269-275.
Fethi Bel Haj. 2008. Chemical composition, antibacterial and antifungal activities of Trichoderma spp growing in Tunisia. Annals of Microbiology 58:303-308.
Gravel V, Martinez C, Antoun H, Tweddell RJ. 2005. Biological Control 50:771–786.
Harman GE, Petzoldt R, Comis A, Chen J. 2004. Interactions between Trichoderma harzianum strains T22 and maize inbred line Mo17 and effects of these interactions on diseases caused by Pythium ultimum and Colletotrichum graminicola. Phytopathology 94:147-153.
Hastuti RD, Lestari Y Suwanto A, Saraswati R. 2012. Endophytic Streptomyces spp. as Biocontrol Agents of Rice Bactrial Leaf Blight Pathogen (Xanthomonas oryzae pv. oryzae). Hayati Journal of Biosciences 19(4):155-162
Intana W, Yenjit P, Suwanno T, Sattasakulchai S, Suwanno M, Chamswarng C. Efficacy of antifungal metabolites Bacillus spp. for controlling tomato damping- off caused by Pythium aphanidermatum. Walailak Journal Science and Technology 5(1):29-38.
Jegathambigai V, Wilson RS, Wijeratnam, RLC Wijesundera. 2009. Trichoderma as a seed treatment to control Helminthosporium leaf spot disease of Chrysalidocarpus lutescens. World Journal of Agricultural Sciences 5:720-728.
Ji XL, Lu GB, Gai YP, Zheng CC, Mu ZM. 2008. Biological control against bacterial wilt and colonization of mulberry by an endophytic Bacillus subtilis strain. FEMS. Microbiology Ecology 65:565-573.
Jones JB, Bouzar H, Stall RE, Almira EC, Roberts PD, Bowen BW, Sudberry J, Strickler PM, Chun J. 2000. Systematic analysis of xanthomonads (Xanthomonas spp.) associated with pepper and tomato lesions. International Journal of Systematic and Evolutionary Microbiology 50:1211-9.
Jones JB, Pohronezny K, Stall RE, Jones JP. 1986. Survival of Xanthomonas campestris pv. vesicatoria in Florida on tomato crops residue, weeds, seeds and volunteer tomato plants. Phytopathology 76:430-434.
Kloepper JW, Leong J, Teintze M, Schroth MN. 1980. Enhanced plant growth by siderophores produced by plant growth promoting rhizobacteria. Nature 286:885-886.
Laha GS. 1994. Role of fluorescent pseudomonads in reducing the deleterious microorganisms associated with seeds and seedling of cotton. Ph.D. Thesis, IARI, New Delhi.
Leelavathi MS, Vani L, Pascal R. 2014. Antimicrobial activity of Trichoderma harzianum against bacteria and fungi. International Journal of Current Microbiology and Applied Sciences 3(1):96-103.
Lemessa F, Zeller W. 2007. Screening rhizobacteria for biological control of Raistonia solanacearum in Ethiopia. Biological Control 42:336-344.
Maketon M, Apisitsantikul J, Siriraweekul C. 2008. Greenhouse evaluation of Bacillus subtilis AP-01 and Trichoderma harzianum AP-001 in controlling tobacco disease. Brazilian Journal of Microbiology 39(2):296-300.
McGuire RG, Jones JB, Sasser M. 1986. Tween media for semiselective isolation of Xanthomonas campestris pv. vesicatoria from soil and plant material. Plant Disease 70:887-91.
Mishghi IJ, Olsen MW, Billotte JM, Sonoda RM. 1992. The importance of rhizobacterial mobility in biocontrol of bacterial wilt of tomato. Soil Biology Biochemistry 24:287-293.
Mondal KK, Singh RP, Verma JP. 1999. Beneficial effects of indigenous cotton rhizobacteria on seed germinability, growth promotion and suppression of bacterial blight disease. Indian Phytopathology 52:228-235.
Montealegre J, Valderrama L, Sánchez S, Herrera R, Besoain X, María Pérez L. 2010. Electronic Journal of Biotechnology 13(2):1-11.
Monteiro L, Rosa de Lima Ramos Mariano, Ana Maria Souto-Maior. 2005. Brazilian Archives of Biology and Techonology 48(1):23-29.
Mortensen CN. 1994a. Seed health testing for bacterial pathogens. Danish Government institute of seed pathology for developing countries (DGISP), Copenhagen, Denmark, pp 68.
Mortensen CN. 1994b. Seed bacteriology laboratory guide. Danish government institute of seed pathology for developing countries (DGISP), Copenhagen, Denmark, pp. 102.
Mukherjee PK, Horwitz BA, Herrera-Estrella A. 2013. Trichoderma research in the genome era. Annual Review of Phytopathology 51:105–129.
Nashwa MA, Sallam KAM, Abo-Elyousr, MAE Hassan. 2008. Evaluation of Trichoderma Species as biocontrol Agents for damping-off and wilt diseases of Phaseolus vulgaris L. and Efficacy of suggested formula. Egyptian Journal of Phytopathology 36:81-93.
Nath R, Dutta S, Laha SK. 2004. Pseudomonas fluorescens - A potential biocontrol weapon to combat bacterial wilt of tomato. Journal of Mycology and Plant Pathology 34(3):974.
Neergaard P. 1977. Seed Pathology. The MacMillan Press Ltd., London, 1187.
Parshikov IA, Moody JD, Freeman JP, Lay JO, Williams AJ, Heinze TM, Sutherland JB. 2002. Formation of conjugates from ciprofloxacin and norfloxacin in cultures of Trichoderma viride. Mycologia 94(1):1- 5.
Patro T SSK, Bahadur P, Jindal JK. 2004. Population dynamics of mungbean phylloplane Bacillus spp. their antagonism and protective action against bacterial leaf spot disease. Journal of Mycology and Plant Pathology 34(3):769-772.
Pohronezny K, Hewitt M, Infante J, Datnoff L. 1992. Wind and wind generented sand injury as factors in infection of pepper by Xanthomonas campestris pv. vesicatoria. Plant Diseases 76:1037-1039.
Ramamoorthy V, Raguchander T, Samiyappan R. 2002. Enhancing resistance of tomato and hot pepper to Pythium diseases by seed treatment with fluorescent Pseudomonads. European Journal of Plant Pathology 108:429.
Ravnikar M, Demsar T, Dreo T. 2001. Laboratory diagnosis of bacterial spot on tomato and pepper. In proceedings of the 5th Slovenian conference on plant protection, Catez of Savi, Slovenia, 6-8 March, 2001.
Richardson MJ. 1990. An annotated list of seed-borne diseases (4th edn). Proceedings International Seed Testing Association Zurich, Switzerland.
Roberts PD, Momol MT, Ritchie L, Olson SM, Jones JB, Balogh B. 2008. Evaluation of spray programs containing famoxadone plus cymoxanil, acibenzolar-Smethyl, and Bacillus subtilis compared to copper sprays for management of bacterial spot on tomato. Crop Protection 27(12):1519-1526.
Ruano-Rosa D, Cazorla FM, Bonilla N. 2014 et al.: Biological control of avocado white root rot with combined applications of Trichoderma spp. and rhizobacteria. European Journal of Plant Pathology 138(4):751–762.
Saettler AW, Schaad NW, Roth DA. 1989. Detection of bacteria in seed (edt.). APS Press, St. Paul, Minnesota, pp. 122.
Safiazov JS, Manners RN, Sattarova RK. 1995. The use of the best antagonists for the control of cotton diseases. Field Crops Research 43:51-54.
Schaad NW. 1988. Laboratory guide for identification of plant pathogenic bacteria (2nd edn). APS Press, St. Paul, Minnesota pp. 164.
Sharma DK. 2007. Seed-borne and post-harvest bacterial diseases of chilli (Capsicum spp.) and tomato (Lycopersicon esculentum Mill.) crops and there management, Ph.D. Thesis, Univ. of Rajasthan, Jaipur.
Shekhawat GS, Gadewar AV, Chakrabrati SK. 1992. Spontaneous phenotypic reversion from affudial to fludial state in strain Pseudomonas solanacearum. ACIAR Bacterial Wilt Newsletter 8:5-9.
Shekhawat GS, Kishore V, Garg ID, Singh R, Sharma AK. 1983. Studies on brown rot, soft rot and common scab. Central Potato Research Institute, Shimla, Annu. Science Report 95-102.
Shekhawat PS, Chakravarti BP. 1976. Factors affecting development of bacterial leaf spot of chilli caused by Xanthomonas vesicatoria. Indian Phytopathology 29:392-397.
Shekhawat PS, Chakravarti BP. 1977. Assessment of loss, symptomology and occurrence of bacterial leaf spot of chillies caused by Xanthomonas vesicatoria in Rajasthan. Indian Journal of Mycology and Plant Pathology 7:11-14.
Sivamani E, Anuratha CS, Gnanamanickam SS. 1987. Toxicity of Pseudomonas fluorescens towards bacterial pathogens of bananas (Pseudomonas solanacearum) and rice (Xanthomonas campestris pv. oryzae). Current Science 56:547-548.
Tapwal A, Singh U, Singh G et al. 2011: In vitro antagonism of Trichoderma viride against five phytopathogens. Pest Technology 5(1):59–62.
Thieme, Frank et al. 2005. Insights into Genome Plasticity and Pathogenicity of the Plant Pathogenic Bacterium Xanthomonas campestris pv. vesicatoria revealed by the complete genome sequence. Journal of Bacteriology 187(21):7254–7266.
Thind BS, Singh P. 2004. Pseudomonas fluorescens - A promising agent for biocontrol of bacterial blight of rice. Indian Journal of Mycology and Plant Pathology 34(3):973.
Unnamalai N, Gnanamankan SS. 1984. Pseudomonas fluorescens is antagonistic to Xanthomonas citri (Hasse.) Dye, the incitant of citrus canker. Current Science 53:703-704.
Wulff EG, Mguni CM, Mortensen CN, Keswani CL, Hockenhull J. 2002. Biological control of black rot (Xanthomonas campestris pv. campestris) of brassica with anantagonistic strain of Bacillus subtilis in Zimbabwe. European Journal of Plant Pathology 108(4):317-325.